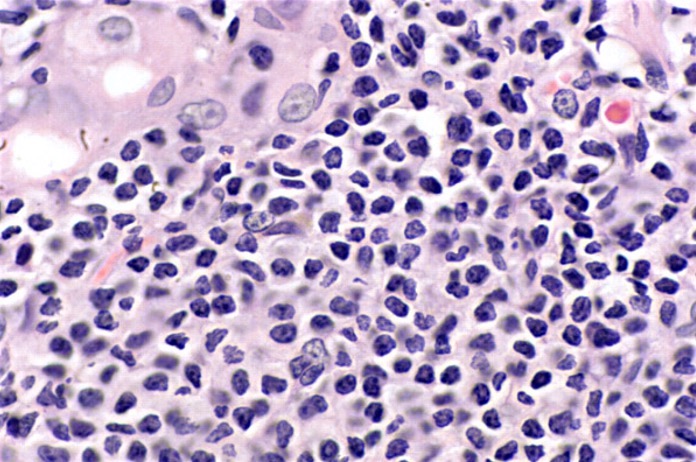

Table of Contents
Definition / general | Essential features | Terminology | ICD coding | Epidemiology | Sites | Etiology | Clinical features | Diagnosis | Prognostic factors | Case reports | Treatment | Gross description | Microscopic (histologic) description | Microscopic (histologic) images | Positive stains | Negative stains | Molecular / cytogenetics description | Molecular / cytogenetics images | Sample pathology report | Differential diagnosis | Board review style question #1 | Board review style answer #1 | Board review style question #2 | Board review style answer #2 | Board review style question #3 | Board review style answer #3Cite this page: Bahceci D, Wen KW. Extranodal marginal zone lymphoma of mucosa associated lymphoid tissue (MALT lymphoma). PathologyOutlines.com website. https://www.pathologyoutlines.com/topic/stomachMALT.html. Accessed April 26th, 2024.
Definition / general
- Extranodal lymphoma composed of morphologically heterogeneous small B cells, including marginal zone (centrocyte-like) cells, cells resembling monocytoid cells, small lymphocytes and scattered immunoblasts and centroblast-like cells (Swerdlow: WHO Classification of Tumours of Haematopoietic and Lymphoid Tissues, 4th Edition, 2017)
Essential features
- Stomach is the most common site involved by MALT lymphoma
- Most gastric MALT lymphomas associated with gastritis caused by Helicobacter pylori infection
- Microscopic features: centrocyte-like cells, monocytoid cells, plasma cells, occasional large transformed lymphocytes, lymphoepithelial lesions, adjacent nonneoplastic germinal centers
- Atypical features of lymphoid infiltrate help distinguish MALT lymphoma from reactive conditions, such as H. pylori gastritis (J Clin Pathol 2007;60:361)
Terminology
- Also called MALToma
ICD coding
- ICD-10: C88.4 - Extranodal marginal zone B cell lymphoma of mucosa associated lymphoid tissue (MALT lymphoma)
Epidemiology
- 7 - 8% of all B cell non-Hodgkin lymphomas (Leuk Lymphoma 2013;54:1891)
- Median age: seventh decade
- M:F = ~1:1
- Up to 50% of primary gastric lymphomas
- 85 - 90% of all GI MALT lymphomas
Sites
- Stomach (35%) is most common site of extranodal marginal zone lymphoma (Blood 2016;127:2082)
- Ocular adnexa (13%)
- Lung (9%)
- Skin (9%)
- Salivary glands (8%)
Etiology
- Related to chronic inflammatory disorders driven by infectious agents or autoimmune stimuli (Blood 2016;127:2082)
- Stomach: H. pylori associated gastritis
- H. pylori infection attracts B cells, T cells and neutrophils to the gastric mucosa; B cell proliferation is driven by reactive T cells, as well as by cytokines
- Chronic proliferative state of these B cells, as well as neutrophil mediated release of reactive oxygen species in areas of chronic inflammation, induces additional oncogenic events that eventually make lymphoproliferation independent of antigenic stimulation
- Additional genetic alterations can ultimately result in transformation to clinically aggressive diffuse large B cell lymphoma (Nat Rev Gastroenterol Hepatol 2010;7:336)
Clinical features
- Can be asymptomatic or cause epigastric pain, anorexia, weight loss, anemia, early satiety, occasionally fever and night sweats
- Most are low stage (stage I and II) at presentation
- 23 - 40% of patients may present with disseminated disease, involving other mucosal sites, lymph nodes or bone marrow (Blood 2000;95:802)
- > 75% of cases will regress with successful treatment for H. pylori
- Increased risk has been reported in patients with chronic hepatitis C virus (HCV) infection (Blood 2016;127:2082)
Diagnosis
- Diagnostic workup includes endoscopic findings, histology with immunohistochemistry and molecular analysis
Prognostic factors
- Indolent
- Lugano staging system: most widely accepted staging system (UpToDate: Treatment of Extranodal Marginal Zone Lymphoma of Mucosa Associated Lymphoid Tissue (MALT Lymphoma) [Accessed 10 February 2021])
- Recurrences may involve other extranodal sites
- BIRC3-MALT1 translocation is associated with H. pylori treatment resistance
- Histologic transformation, defined as an infiltration of 50% or more of large B cells, occurs in 8% of patients during the course of the disease (Mod Pathol 2013;26:182)
Case reports
- 32 year old man presented with epigastric pain of 6 months duration (BMC Gastroenterol 2002;2:6)
- 58 year old woman was referred with epigastric pain and 10 kg weight loss (Histopathology 1995;27:89)
- 72 year old woman presented with a 10 month history of intermittent epigastric discomfort without vomiting, anorexia or weight loss (J Clin Pathol 2002;55:548)
Treatment
- H. pylori eradication - first line therapy (Gut 2012;61:507)
- Curative in majority of gastric MALT lymphomas
- Resolution can take up to 24 months
- Some primary gastric diffuse large B cell lymphomas may also respond to antibiotic eradication therapy alone
- If H. pylori eradication therapy fails → second line therapy (Med Oncol 2010;27:291)
- Chemotherapy
- Radiation
- Surgery: only necessary if complications (perforation, obstruction, bleeding) occur
Gross description
- Large mass with or without ulcer
- Diffusely thickened gastric wall
- Polypoid lesions
Microscopic (histologic) description
- Mass lesion with the following features
- Sheets of neoplastic small lymphocytes
- Irregular / angulated nuclear contours with inconspicuous nucleoli (centrocyte-like)
- Relatively abundant pale cytoplasm (monocytoid appearance)
- Cells with plasmacytic differentiation
- Clonally related to the small lymphocytes
- ~33% of gastric lymphomas
- Intranuclear (Dutcher bodies) or intracytoplasmic (Russell bodies) immunoglobulin inclusions can be seen
- Nuclear polymorphism may be noted
- May see occasional transformed lymphocytes resembling centroblasts and immunoblasts
- Larger nuclei with more open chromatin and prominent nucleoli
- If solid or sheet-like proliferations of transformed cells → diffuse large B cell lymphoma (Arch Pathol Lab Med 2018;142:44)
- Lymphoepithelial lesions (specific but not sensitive)
- Infiltration of gastric glands by neoplastic lymphocytes (> 3 centrocyte-like cells causing epithelial damage)
- Residual gastric glands are separated by the neoplastic lymphocytes
- Oxyphilic change (eosinophilic degeneration) of epithelial cells
- May lead to destruction of glands
- Adjacent reactive germinal centers
- Neoplastic cell colonization may resemble follicular lymphoma
- Amyloid deposition can be seen (Am J Clin Pathol 2012;137:51)
- H. pylori gastritis associated changes can often be present in biopsies from patients
- Active or chronic inflammation
- Diffuse chronic monocytic infiltrate, microerosions, large lymphoid follicles and regenerative foveolar hyperplasia
Microscopic (histologic) images
Contributed by Kwun Wah Wen, M.D., Ph.D.
Positive stains
- Neoplastic cells of MALT lymphoma: CD19, CD20, CD22, CD79a, CD43 variable, BCL2 (Arch Pathol Lab Med 2018;142:44)
- Kappa / lambda: can be useful to demonstrate light chain restriction (especially if there are abundant neoplastic plasma cells)
- Staining for CD21, CD23 and CD35 typically reveals disrupted and occasionally expanded meshwork of intermixed follicular dendritic cells, which may help to recognize colonized follicles
- Keratin: can accentuate lymphoepithelial lesions
- Congo red: can highlight amyloid deposition present in a subset of cases
- MNDA staining: MALT (61 - 75%) versus follicular (< 10%) lymphoma (Am J Clin Pathol 2019;151:337)
- IRTA1 antibody: potential MALT specific antibody
Negative stains
- CD5, CD10 (rarely can be positive), BCL6, BCL1 / cyclin D1 (rules out mantle cell lymphoma) (Arch Pathol Lab Med 2018;142:44)
Molecular / cytogenetics description
- PCR can help confirm clonally rearranged immunoglobulin genes in challenging cases (those that show no aberrant expression of CD43 and BCL2)
- t(11;18)(q21;q21): BIRC3 (API2)-MALT1 (6 - 26%) (Haematologica 2019;104:e558)
- Associated with resistance to H. pylori eradication therapy
- t(14;18)(q32;q21): IGH-MALT1 (1 - 5%)
- t(1;14)(p22:q32): BCL10-IGH (not seen in gastric cases)
- t(3;14)(p13;q32): FOXP1-IGH (not seen in gastric cases)
- Trisomy 3 (11%)
- Trisomy 18 (6%)
- TNFAIP3 deletion / hypermethylation
- Point mutations in Ig genes
Sample pathology report
- Gastric ulcers, biopsy:
- Extranodal marginal zone lymphoma (MALT lymphoma) (see comment)
- Comment: H&E sections of the biopsy show patchy involvement by a dense and atypical lymphoplasmacytic infiltrate with lymphoepithelial lesions. The background stomach shows chronic active gastritis. No carcinoma, dysplasia, Helicobacter organisms or intestinal metaplasia is present.
- Immunostains were performed and evaluated with the following results:
- CD3: Highlights background small reactive T cells.
- CD20: Highlights diffuse sheets of neoplastic B cells in some fragments.
- CD21: Highlights rare residual dendritic cell meshworks underlying one lymphoid follicle.
- Kappa: Highlights B cells and plasma cells with kappa restriction (kappa:lambda ratio > 8:1).
- Lambda: Highlights a rare subset of B cells and plasma cells (kappa:lambda ratio > 8:1).
- H. pylori: Negative.
- CD5: Negative in B cells; positive in background T cells.
- CD10: Negative in B cells.
- CD43: Negative in B cells; positive in T cells.
- BCL1: Negative for mantle cell lymphoma.
- BCL2: Positive in B cells and T cells.
- CD23: Negative in B cells.
- Ki67: Low proliferative index.
- AE1 / AE3: Negative for carcinoma.
- The above findings support the interpretation of extranodal marginal zone lymphoma in the stomach.
Differential diagnosis
- Severe H. pylori gastritis / reactive lymphoid hyperplasia:
- No clonal B cell populations demonstrated by light chain restriction
- No sheets of monocytoid or monomorphous cell populations
- No abnormal plasma cells with nuclear irregularities
- No lymphoepithelioid lesions
- CLL / SLL:
- Mantle cell lymphoma:
- Lymphocytes intermediate in size with irregular contours
- Stains: CD5+, cyclin D1 / BCL1+, SOX11+
- Follicular lymphoma:
- Reactive germinal centers colonized by MALT can mimic follicular lymphoma (Surg Pathol Clin 2017;10:1021)
- Stains: CD10+, BCL6+, BCL2 variable
- Lymphoplasmacytic lymphoma:
- Histologic and immunohistochemical features overlap; monocytoid B cells and centrocyte-like neoplastic cells are more common in gastric MALToma
- MYD88 L265P mutation, serum protein study
- Russell body gastritis (J Clin Pathol 2006;59:1316):
- Polyclonal immunoreactive pattern to immunoglobulin light chains
Board review style question #1
You are asked to consult on a 55 year old patient with mucosa associated lymphoid tissue (MALT) lymphoma of the stomach. She is H. pylori positive. PET-CT does not show any other evidence of disease outside the stomach. The lesion is 5 - 6 cm and confined to fundus. A bone marrow biopsy is negative. Which of the following statements about MALT lymphoma is true?
- Combination chemotherapy is used as the first curative approach
- Gastric MALT may progress into diffuse large B cell lymphoma
- H. pylori infection is associated with gastric MALT in a minority of cases
- Most patients present with multi-organ involvement
Board review style answer #1
B. Gastric MALT may progress into diffuse large B cell lymphoma
Comment Here
Reference: MALT lymphoma
Comment Here
Reference: MALT lymphoma
Board review style question #2
Which cytogenetic / molecular abnormality of gastric MALT lymphoma is associated with resistance to H. pylori antibiotic treatment?
- t(11;18)(q21;q21): BIRC3-MALT1
- t(14;18)(q32;q21): IGH-MALT1
- TNFAIP3 deletion / hypermethylation
- Trisomy 3
Board review style answer #2
Board review style question #3
Which of the following is true regarding MALT lymphoma of the stomach?
- Evidence of H. pylori infection should only be sought in the presence of symptoms, such as dyspepsia, bloating, nausea
- Lymphomas with sheets of large cells should be diagnosed as high grade MALT lymphoma
- Neoplastic lymphocytes are positive for CD5 and cyclin D1
- Neoplastic lymphocytes ranging from small lymphocytic to monocytoid cells infiltrating into epithelial structures are characteristic for gastric MALT lymphoma
Board review style answer #3
D. Neoplastic lymphocytes ranging from small lymphocytic to monocytoid cells infiltrating into epithelial structures are characteristic for gastric MALT lymphoma
Comment Here
Reference: MALT lymphoma
Comment Here
Reference: MALT lymphoma